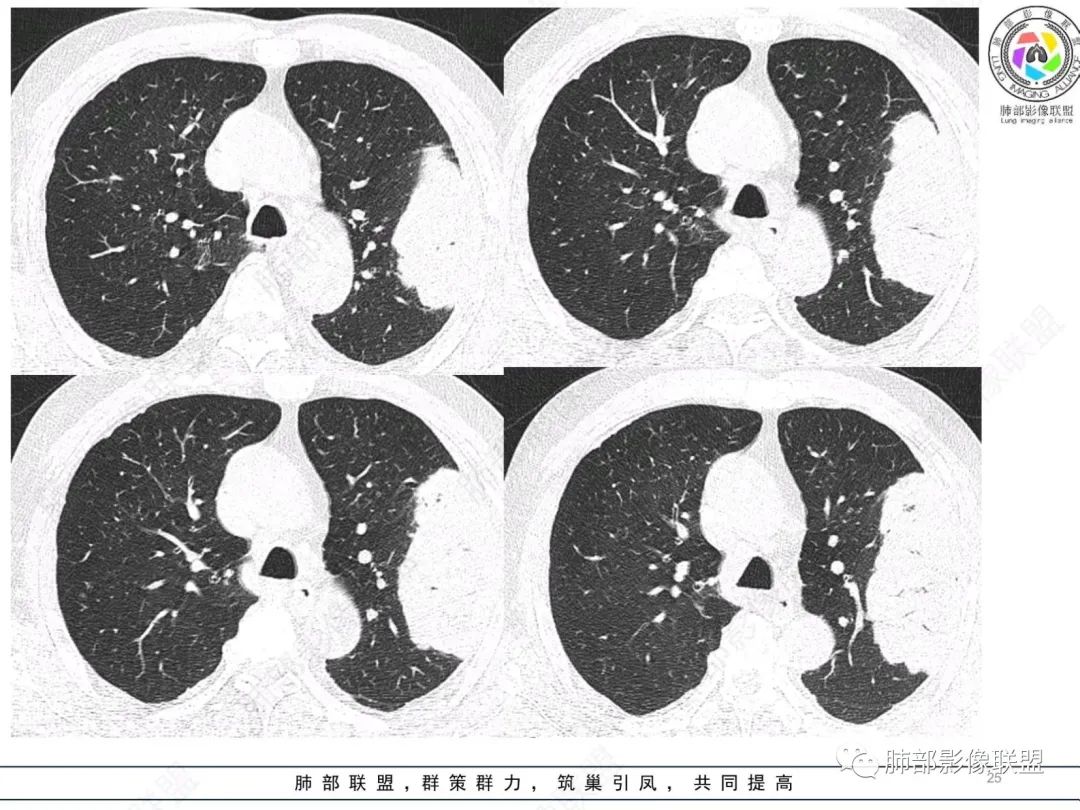
【病例】肺部硕大块影一定想到它！-24
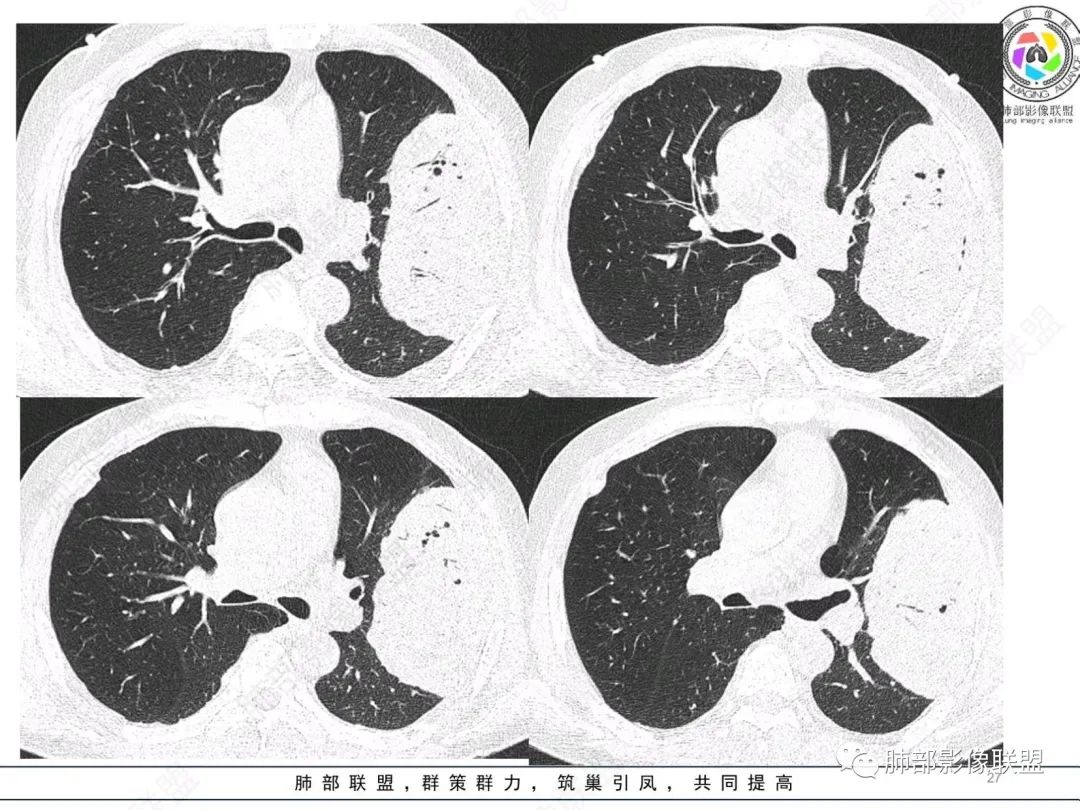
【病例】肺部硕大块影一定想到它！-26

【病例】肺部硕大块影一定想到它!
发布时间:2022-10-20
发布时间:2022-10-20
病例资料

微信群讨论实录
谢加平:
左肺上叶大肿块,膨胀性生长,边界清,密度较低,见部分坏死区,强化弱,肿块见支气管充气V扩张征,分布僵直,枯树枝特点,另一个重要特点血管造影征,淋巴瘤,肿块长轴与胸膜平行,与隐球菌鉴别,隐球荚膜抗原检查,明确诊断经皮肺穿刺。另胸膜钙化(问诊既往有无患胸膜炎病史)。
如果粘液腺Ca,周边太干净了,不支持。
放射小白:
老年男性左肺团块状占位,首先会考虑肉瘤/肉瘤样癌,其次大细胞肺癌,最后不排除肺结核。
飞鹰行动:
老年男性,糖尿病病史,消瘦、乏力三个月,影像表现左肺上叶胸膜下团块,有一定张力,内部疏松,可见支气管影及坏死区,增强病灶边缘环形强化,内部未见强化,考虑炎性肉芽肿病变,隐球?奴卡?放线菌?鉴别淋巴瘤。
宇宙:
左肺上叶胸膜下肿块,宽基底与胸膜相连,跨叶裂,边缘清晰膨隆,其内支气管充气,部分扩张、僵直,无明显强化,血管造影征,考虑淋巴瘤,鉴别腺癌
小兜:
左肺胸膜下巨大占位,跨叶裂,宽基底与胸膜相连,胸膜钙化,平扫密度较低,强化不明显,可见内部血管显影,支气管充气征和扩张,考虑为恶性,倾向于淋巴瘤
秦化君:
增强没有强化,血管束正常,气管束有正常有扩张,内有空洞,考虑炎性病变,隐球?
丽:
左侧胸腔巨大肿块,跨叶生长,临近胸膜钙化,边缘模糊,可见支气管影,定位肺内,增强后轻度强化,边缘见血管影,考虑淋巴瘤,鉴别肉瘤
那个人:
老年,明显消瘦,左侧胸廓轻度缩小?胸膜增厚,见钙化,以前结核?接触其他?整个肿块膨隆,坏死不明显,支气管通畅,轻度扩张轻度强化,考虑恶性,淋巴瘤可能
放射线:
左肺上叶胸膜下肿块,膨胀性生长,边界清晰,密度不均部分坏死,未见强化,病灶内支气管迂曲扩张,病灶长轴与胸膜平行,胸膜下脂肪间隙存在,胸膜钙化,考虑放线菌?毛霉?鉴别淋巴瘤
衡妈:
支持淋巴瘤,左上肺大肿块,有分叶,边缘光整,病灶内密度不均,可见支气管扩张征,增强后可见血管影征。周围肺野清晰。
赵春杨:
左肺上叶肿块,宽基底与胸膜相连,跨叶裂,边缘清晰膨隆,可见小分叶,其内支气管充气,部分扩张、僵直,呈枯枝征,支气管达边征,增强无明显强化,可见血管造影征,考虑恶性病变,淋巴瘤,鉴别粘液腺癌。
361度:
左肺团块样病灶,分叶,膨隆,不规则空洞,支气管枯枝样,血管造影征,考虑恶性,腺癌(肺肠型)。
宇宙:
左肺上叶胸膜下肿块,宽基底与胸膜相连,跨叶裂,边缘清晰膨隆,其内支气管充气,部分扩张、僵直,无明显强化,血管造影征,考虑淋巴瘤,鉴别腺癌
放射线:
左肺上叶胸膜下肿块,膨胀性生长,边界清晰,密度不均部分坏死,未见强化,病灶内支气管迂曲扩张,病灶长轴与胸膜平行,胸膜下脂肪间隙存在,胸膜钙化,考虑放线菌?毛霉?鉴别淋巴瘤
doctor:
胸膜钙化,提示过去患过结核脓胸,考虑结核脓胸相关淋巴瘤。




尘缘:
支持淋巴瘤。不用鉴别,尤其是粘液腺癌,根本不要考虑,这么大的肿块,周围这么干净,内部也没有明显粘液密度
良孑:
糖尿病史,慢性病程,左肺巨大肿块,跨叶生长,肿块近端可见充气支气管征及悬浮气泡,轻度圴匀强化,病变长轴与胸膜平行,炎性标志物正常,考虑放线菌,其次淋巴瘤
尘缘:
我要修正一下观点了:仔细看了视频,肿块占位效应明显,对周围血管,支气管有推挤,增强后强化不明显,NSE增高,半年体重下降25公斤,虽然有内部支气管扩张,血管漂浮,边界清楚支持淋巴瘤,但强化太低,膨隆,占位推挤太明显(淋巴瘤一般没有这么明显的占位效应),胸膜关系有载桩,恶病质明显(乏力,半年体重下降了25公斤),NSE也明显增高,就不支持淋巴瘤了。还是考虑外朝内的恶性肿瘤,间质来源的肉瘤伴有神经内分泌分化或者大神泌。
不支持淋巴瘤的有四点:1、对周围血管支气管推挤明显。2、胸膜有栽桩,3、强化太弱(淋巴瘤一般还是中度以上甚至高度强化多见),4、NSE升高明显,体重下降太明显。
腺癌一般不会有这么明显的推挤作用的。
Yishion:
淋巴瘤,鉴别间叶来源肿瘤或者神经内分泌肿瘤
wj:
支气管不像淋巴瘤,肺动脉走也不连续。支气管是断断续续的堵塞和扩张,狭窄。不是那种扩张
lily:
老年男性,糖尿病病史,消瘦、乏力三个月,肿瘤标志物高。左肺上叶胸膜下肿块,边界清晰,可见支气管影及坏死区,增强病灶边缘强化,内部未见明显强化,邻近胸膜有累及,考虑恶性,建议穿刺活检。
看图说话:
左肺紧贴胸膜巨大肿块,跨叶裂生长,密度均匀,边缘清晰,内支气管略扩张,增强见血管影,强化不明显,胸膜栽赃,钙化,考虑淋巴瘤。
南边老师分析
南边:





我再建一下血管。支气管进入,但是近端推移,堵塞








南边:
大肿块,边缘光滑,深分叶
近端支气管堵塞、推移为主
部分类似于脐凹征
内部支气管扩张
肺动脉推移为主,边缘部分进入
淋巴瘤符合吗?
尘缘:
淋巴瘤肯定不符合了。
仅仅只有血管漂浮和支扩支持淋巴瘤。其他细节都是否定淋巴瘤的。
南边:
大肿块、表面光滑但深分叶,肺门侧支气管堵塞
我一开始诊断恶性,定在淋巴瘤,还觉得信心满满
回头看,内部支气管近端其实不连续,伴随肺动脉不存在
这两点就不符合
还有如果从支气管的特点考虑黏膜相关性淋巴瘤,其整体应该是边缘不清楚为主,肺炎样为主。
病理结果

南边回顾分析


























知识拓展
原发性肺肉瘤样癌(PSC)一组临床罕见的肺部肿瘤,属于上皮细胞源性肿瘤,仅占肺部恶性肿瘤的0.3%~4.7%。为含有肉瘤形态细胞或肉瘤样分化的非小细胞肺癌,癌成分多为鳞癌或腺癌,肉瘤成分最常见的是纤维肉瘤。
肺肉瘤样癌的CT表现主要特点:
1)部位:周围型或中央型软组织肿块,以周围型为多见,且肿瘤多位于肺上叶。如本例:该肿瘤位于左肺上叶。
2)大小及形态:由于本病恶性程度高,早期症状不明显,发现时肿块均较大。如本例病变巨大。
3)肿块边界和边缘:多较清楚,呈圆形、类圆形,且由于肿块生长速度不均匀,可见分叶,毛刺少见。有报道肿块周围毛玻璃影是多形性癌特征表现。
4)密度:肿块平扫为软组织密度,由于体积较大,内部常见大片状坏死,可出现不规则厚壁空洞或坏死内多发无壁小空洞,坏死多不均匀:坏死灶内可见如柳絮样的斑片样强化灶,坏死边缘与非坏死区分界不清本例坏死较明显,密度不均匀。
5)肿瘤强化方式:肺部恶性肿瘤强化程度与其血供丰富程度相关,血供丰富多强化明显,反之则较差。由于PSC 周边实性部分富血供及内部黏液变性、坏死,增强后肿块多数呈轻-中度边缘环形强化或不均匀小斑片状强化。国外学者对照病理发现肿瘤细胞或胶原组织增强扫描时强化,无强化的低密度区代表了黏液样变性区和出血坏死区。
(赖晓宇老师总结)
参考文献
王猛,田彤彤,朱庆强,等,原发性肺肉瘤样癌的CT表现,中华消
化病与影像杂志,2018,8(5):152-157.
庞颖,夏黎明,曾祥芹,等.肺肉瘤样癌的影像学表现.放射学实践,
2011,26(2):168-171.
卢跃忠,唐向利,吴英哲,等.原发性肺肉瘤样癌的CT表现与鉴别诊断
医学影像学杂志,2018(5).
上一篇:少见的急症—冠状动脉夹层